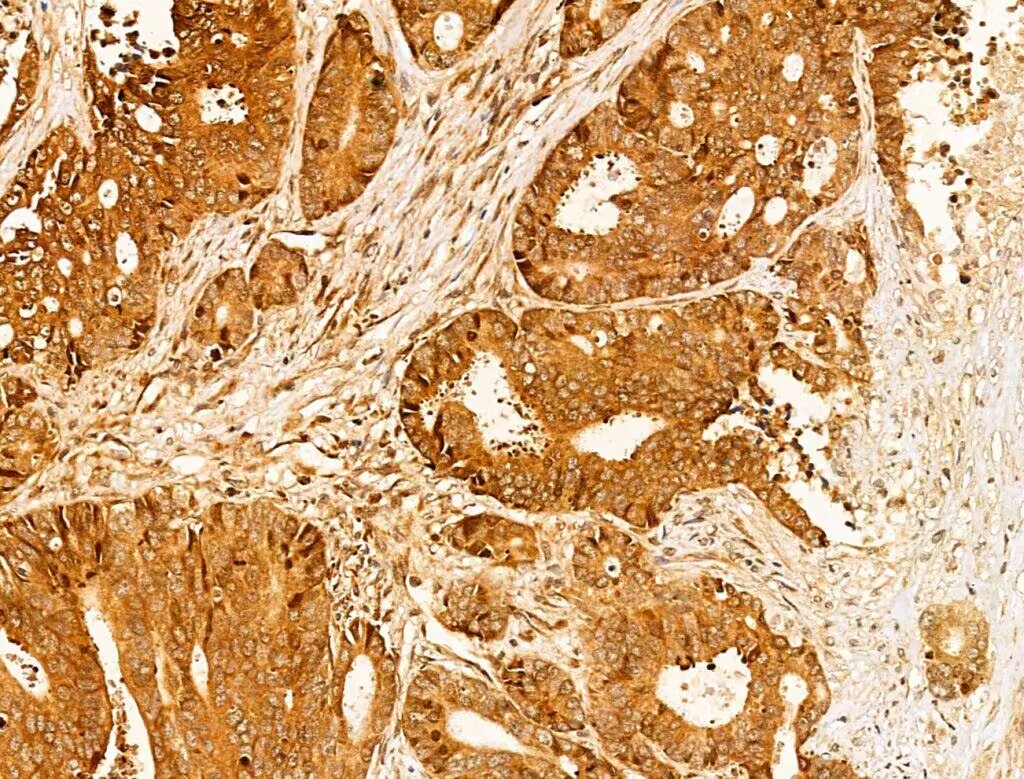
Product Image

worldwide@absin.cn
- Cart 0
- English
Rabbit anti-Cleaved Caspase-1(ALa317)/P10 Polyclonal Antibody
CASP-1; CASP1; CASP1_HUMAN; Caspase 1; Caspase-1 subunit p10; ICE; IL-1 beta-converting enzyme; IL-1BC; IL1 beta converting enzyme; IL1B convertase; Interleukin 1 beta convertase; Interleukin 1B converting enzyme; Interleukin-1 beta convertase; Interleukin-1 beta-converting enzyme; p45;,Cleaved Caspase1 /P10

Reactivity:
Human, Mouse, Rat
Application:
WB, IHC, IF, ICC
Host:
Rabbit
Clonality:
Polyclonal Antibody
- Product Details
- FAQ
- Pictures
- Documents
Tips : This product is for research use only. Not for use in diagnostic prodcedures.